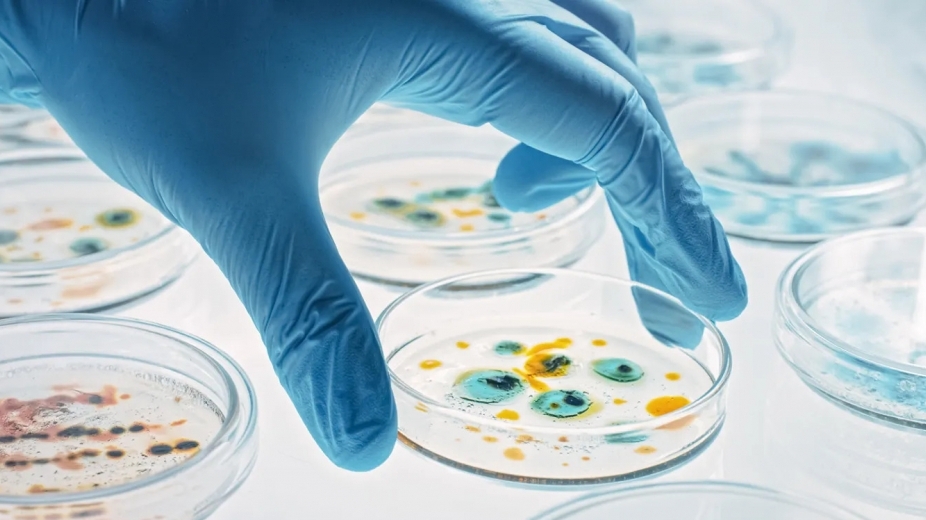
Kháng sinh mới có khả năng tiêu diệt vi khuẩn kháng thuốc mạnh

Những vật dụng thường dùng chứa nhiều vi khuẩn
Bàn chải đánh răng
Bàn chải đánh răng dễ dẫn đến nấm mốc và vi khuẩn do đặt trong phòng tắm ẩm ướt hoặc để ẩm ướt lâu ngày.
 |
Những vi khuẩn này có thể xâm nhập vào cơ thể con người thông qua nuốt trực tiếp hoặc niêm mạc miệng bị tổn thương và sâu răng, gây ra các bệnh như viêm não, nhiễm trùng huyết, bệnh thấp tim và viêm thận. Do đó, chúng ta cần thay đổi bàn chải đánh răng và khăn tắm thường xuyên.
Công tắc đèn và tay nắm cửa
Trên bàn tay chúng ta luôn ẩn chứa rất nhiều vi khuẩn mà bằng mắt thường chúng ta không thể nhìn thấy được.
 |
Trong khi đó, những vật dụng như công tắc đèn và tay nắm cửa là những vùng chúng ta thường xuyên chạm tới nhưng lại rất ít khi dùng xà phòng hay dung dịch sát khuẩn để làm sạch chúng.
Vì vậy mà khi bất cứ thành viên trong gia đình bị nhiễm virus (như cúm) đều có thể lưu lại trên tay nắm cửa hoặc công tắc đèn rồi lây cho cả gia đình.
Vách ngăn tủ lạnh
Các gia đình thường chỉ chú ý vệ sinh bề mặt của tủ lạnh nhưng vách ngăn lại thường bị bỏ qua.
Một cuộc khảo sát cho thấy tỷ lệ phát hiện nấm mốc trong vách ngăn tủ lạnh là 83%, do đó, bạn nên cọ rửa bằng dung dịch tẩy pha loãng hoặc chất khử trùng mỗi tuần một lần.
Bọt biển rửa bát
Chúng ta sử dụng bọt biển hàng ngày để rửa bát đĩa, nồi chảo. Lâu dần vi trùng sẽ lây lan trong bọt biển. Vì vậy, bạn cần thay miếng bọt biển rửa bát mỗi tháng một lần.
Nhiều người còn giảm thiểu chất thải bằng cách cho bọt biển vào lò vi sóng để tiêu diệt vi trùng bằng nhiệt. Tuy nhiên, đây lại là cách để vi khuẩn sinh sôi nảy nở.
Thớt
Một số nghiên cứu cho thấy lượng vi khuẩn ở thớt (đặc biệt là thớt gỗ) nhiều gấp 200 lần vi khuẩn trên bệ toilet.
 |
Bạn cần trang bị 2 chiếc thớt trong nhà, một chiếc để chặt, thái đồ sống và chiếc khác dành cho đồ chín. Bạn phải cọ rửa kỹ và làm khô thớt sau khi rửa. Đối với thớt thái thực phẩm nấu chín, rau củ ăn sống... bạn có thể tẩy sạch bằng nước chanh hoặc hơ thớt trên bếp gas nóng để tiêu diệt các vi khuẩn còn sót lại.
Cây lau nhà
Cây lau nhà là một trong những dụng cụ vệ sinh dễ bị bỏ quên nhất, có lẽ vì mọi người có xu hướng cho rằng cứ nhúng cây lau nhà vào xô nước là đã sạch.
Trên thực tế, chổi lau nhà thường xuyên tiếp xúc với độ ẩm khiến nó trở thành nơi hoàn hảo cho vi khuẩn sinh sôi. Sau đó, bạn lại dùng nó lau khắp nhà vì nghĩ rằng như vậy là đang làm sạch nhà cửa.
Một mẹo làm sạch chổi lau nhà đơn giản là giặt bằng nước và bột giặt/nước giặt sau khi sử dụng. Bạn cũng có thể thêm một ít thuốc tẩy hay bất kỳ chất tẩy rửa nào mà bạn thường dùng. Bạn cần phơi khô chổi lau nhà sau khi sử dụng để hạn chế vi khuẩn sinh sôi.
Khăn lau bếp
Khăn lau bếp là vật dụng quen thuộc, không thể thiếu trong mỗi gia đình. Nhiều gia đình có thường sử dụng khăn lau bếp đến khi rách, bẩn đen mới thay mới.
Nhiều nghiên cứu cho thấy, một chiếc khăn lau bếp nhỏ chứa rất nhiều vi khuẩn có hại như vi khuẩn gây hại cho sức khỏe. Đây thực sự là “ổ vi khuẩn” nếu không được vệ sinh đúng cách.
Để loại bỏ vi khuẩn, cách tốt nhất là bạn ngâm khăn trong nước tẩy trùng trong 15 phút, sau đó giặt khăn với xà bông và đem đi phơi nắng để tiêu diệt vi khuẩn. Thay khăn mỗi tháng một lần. Ngoài ra, nên sử dụng khăn chuyên dụng để lau các đồ vật khác nhau.
Tiền
 |
Trao tay qua nhiều người, từ người bán thịt, cá cho đến cửa hàng rau củ…, tiền ẩn chứa hàng loạt vi khuẩn.
Những người thường xuyên đếm tiền như nhân viên ngân hàng, chủ kinh doanh, thu ngân... nên thường xuyên rửa tay sạch bằng các chất tẩy rửa an toàn. Đồng thời, hạn chế thói quen vừa đếm tiền, vừa đưa tay lên miệng.
Điện thoại di động
Điện thoại di động có thể chứa vi khuẩn nhiều hơn gấp 10 lần so với hầu hết các loại bệ ngồi trong nhà vệ sinh. Nếu bạn mang theo điện thoại vào nhà vệ sinh, thiết bị này có thể bị dính nhiều vi khuẩn từ trong không khí.
Tuy nhiên, ngay cả khi bạn không bao giờ mang điện thoại di động vào, thì nó vẫn bị bao phủ bởi vi khuẩn từ mọi thứ khác xung quanh mà bạn chạm vào và mọi bề mặt mà nó trực tiếp tiếp xúc.